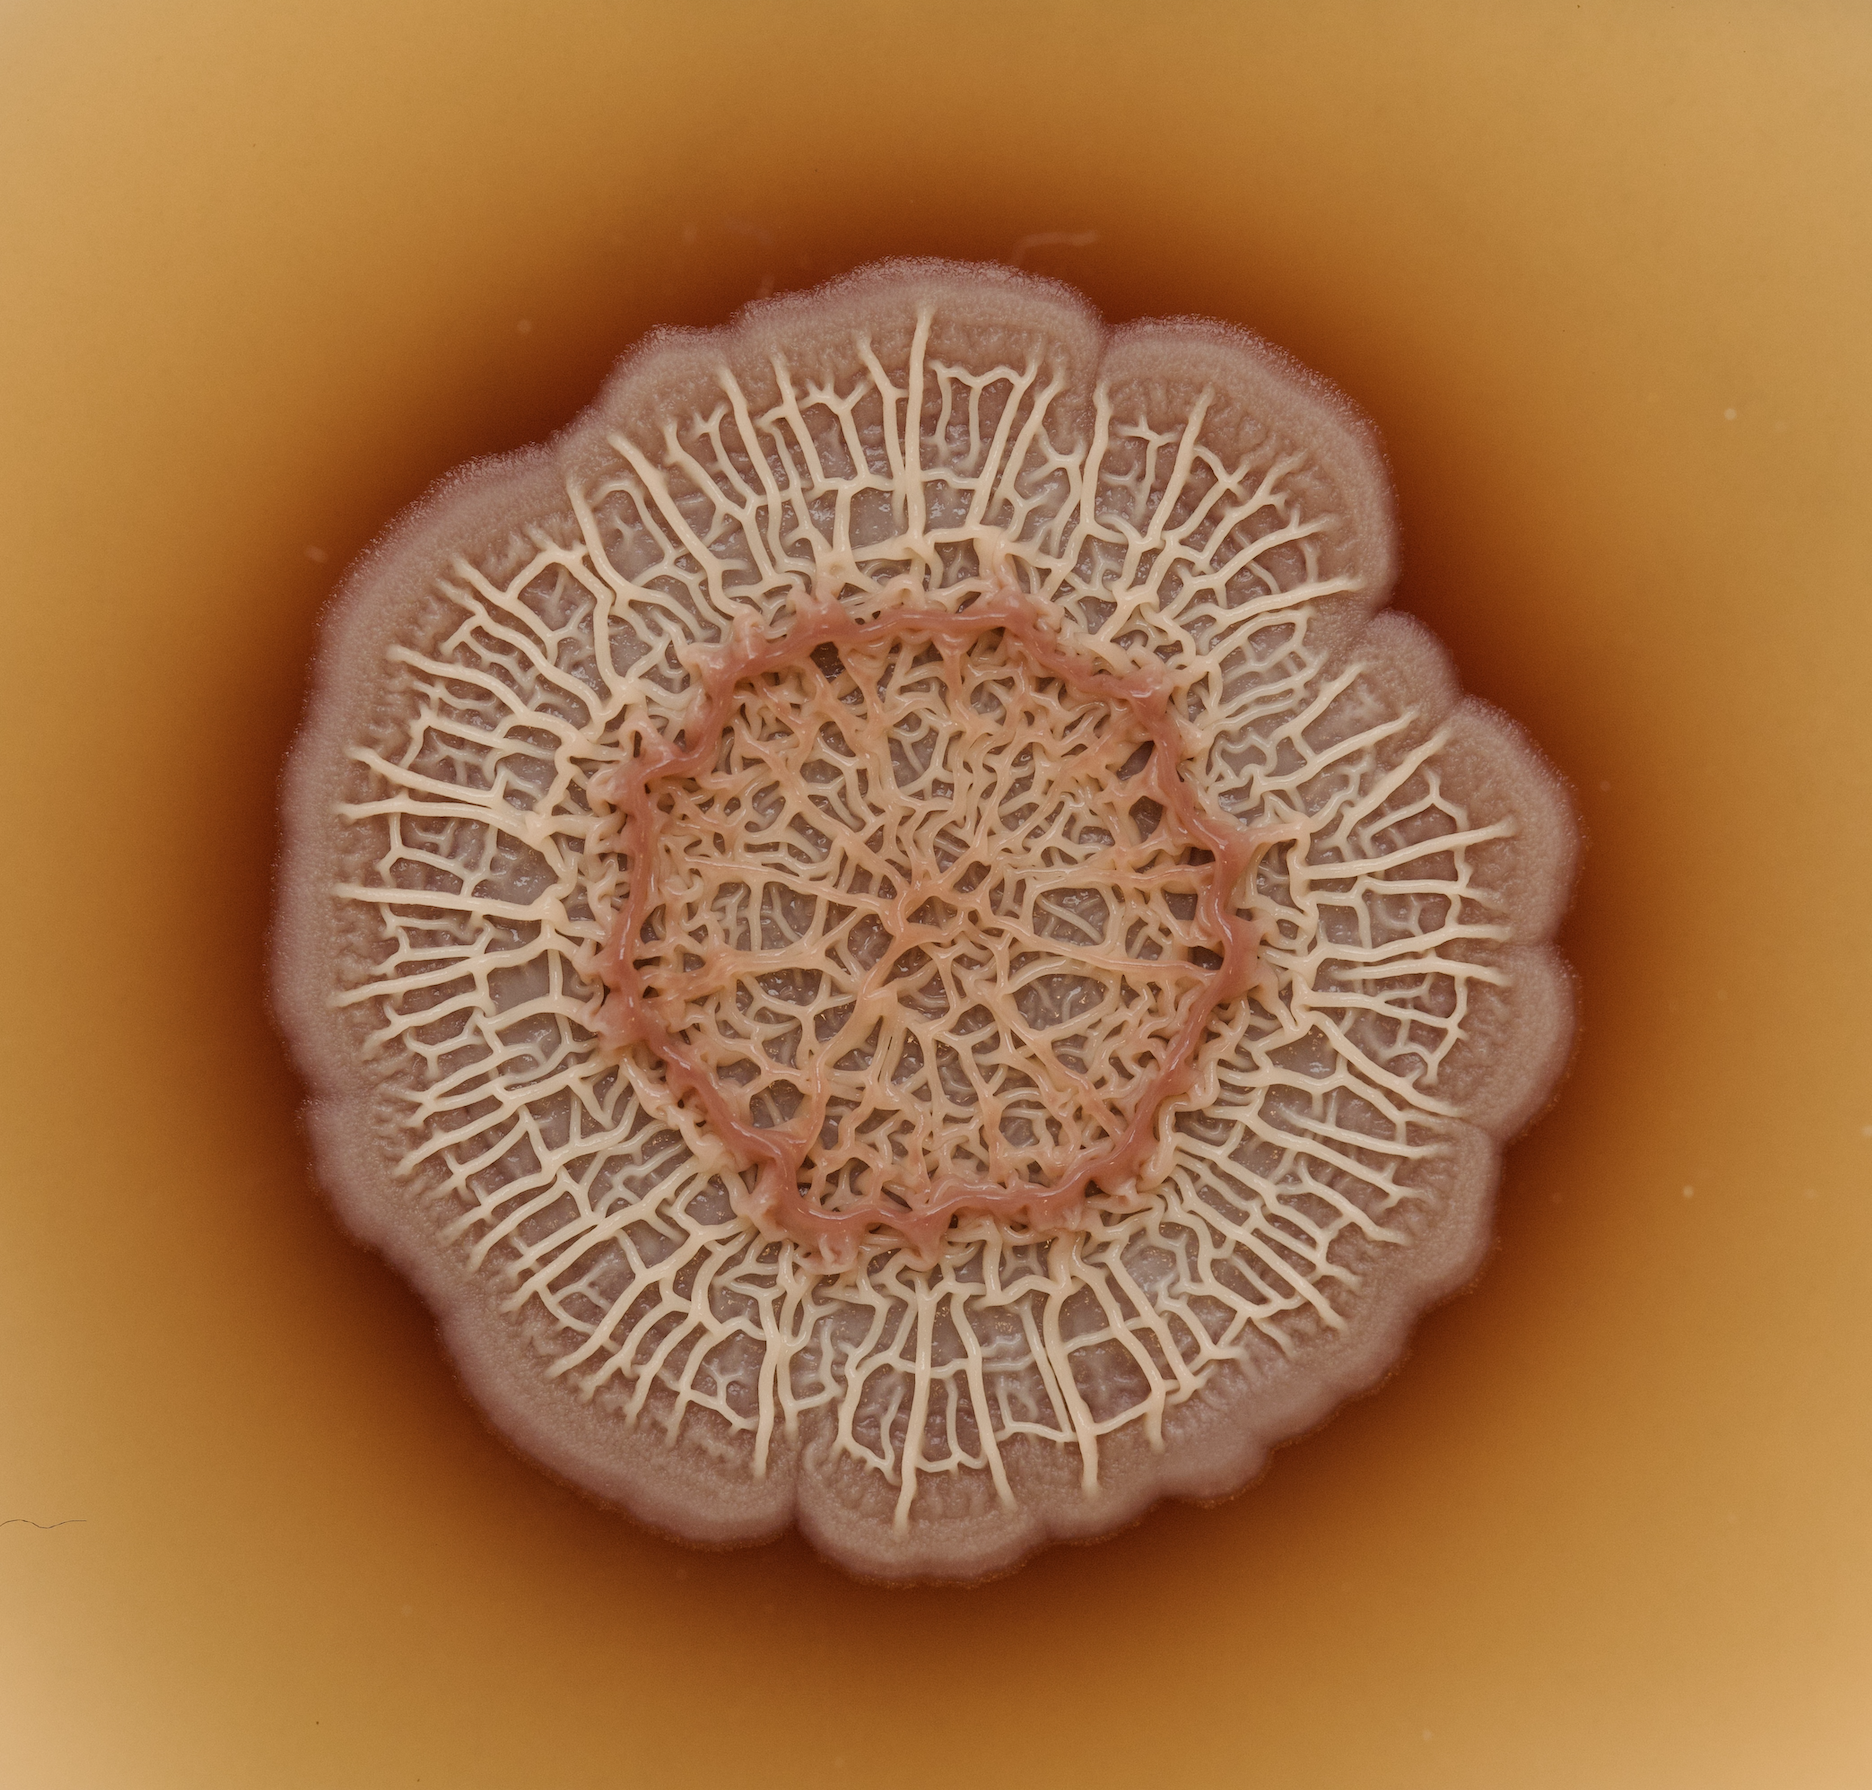

Luma
Free
In 3 days
Meet the Microbes: Inside Andes' Carbon Dioxide Removal Science (+Pastries)
Tuesday, April 21, 2026 · 5:00 PM – 6:30 PM
Andes Ag, Inc., 1210 Marina Village Pkwy, Alameda, CA 94501, USA, Alameda, United States
51 attending
About this event
🔬 Meet the Microbes: Inside Andes’ Carbon Dioxide Removal Science
We’re opening the doors to our Alameda facility for a behind-the-scenes look at the science powering our microbial carbon dioxide removal technology, designed to work with nature, support farmers, and durably remove CO₂ from the atmosphere.
Join us for a tour of our facility, meet members of our team, and get an inside look at how our microbes are turning cropland into a climate solution.
We'll have pastries after!
Learn more at andes.bio
By registering for this event, you agree to share your registration information with the organizers of SF Climate Week.
Sign in to view full event details
Create a free account to see descriptions, save events, and more
Topics & Tags
Climate
Food & Drink
SF Climate Week 2026
Climate
Food & Drink
Date & time
Tuesday, April 21, 2026 · 5:00 PM – 6:30 PM
America/Los_Angeles
Location
Andes Ag, Inc., 1210 Marina Village Pkwy, Alameda, CA 94501, USA, Alameda, United States
America/Los_Angeles
Attendance
51 going · 51 spots
1 spots remaining
Type
independent
SourceLuma
UpdatedApr 18, 2026
About Meet the Microbes: Inside Andes' Carbon Dioxide Removal Science (+Pastries) in Alameda
Meet the Microbes: Inside Andes' Carbon Dioxide Removal Science (+Pastries) is a free independent taking place on Tuesday, April 21, 2026 at Andes Ag, Inc., 1210 Marina Village Pkwy, Alameda, CA 94501, USA, Alameda, United States. Attendance is free — register to secure your spot.